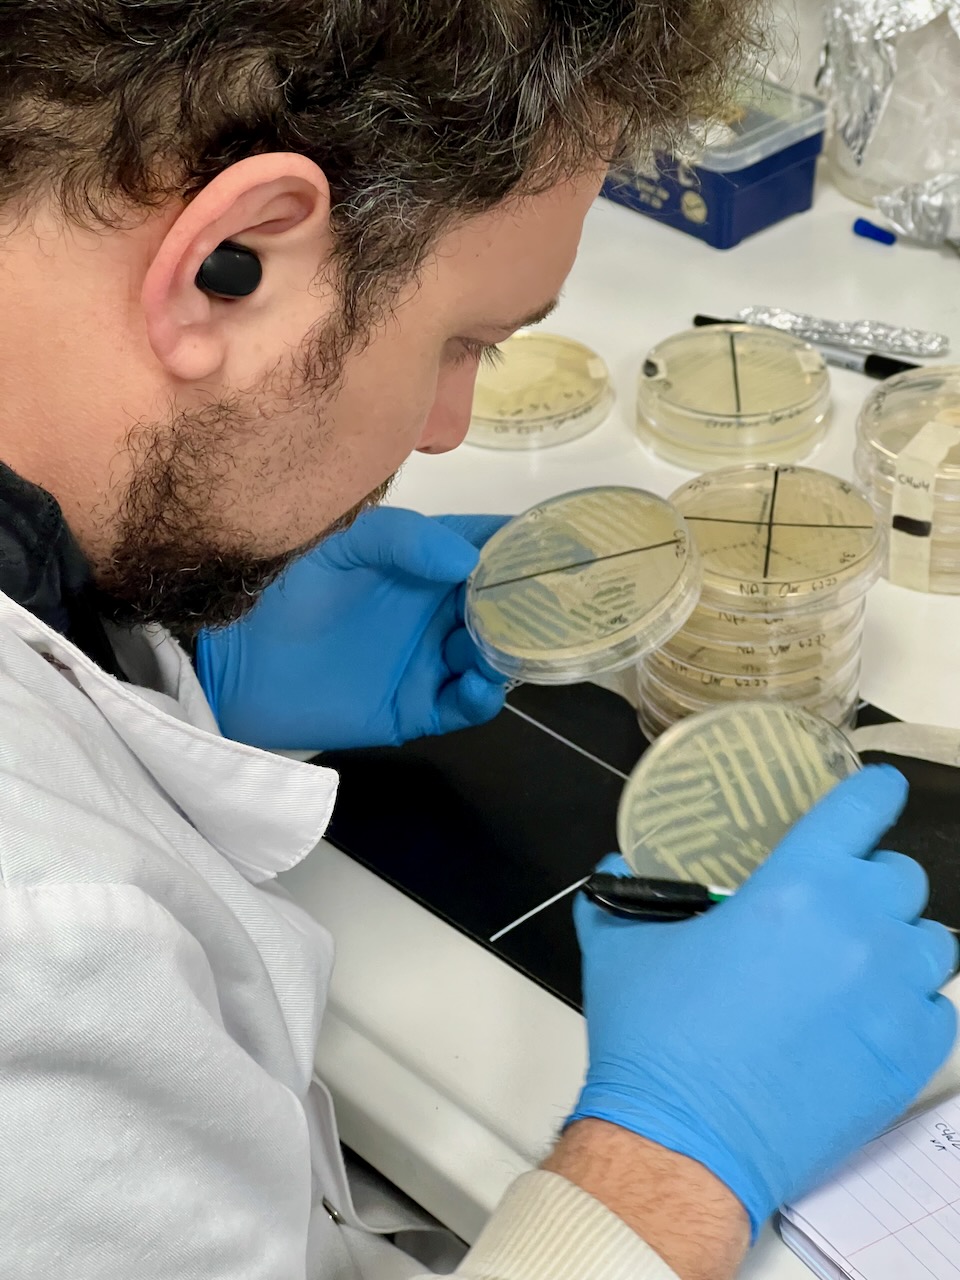

General Information
Sarris Lab was established in 2017 as part of the Institute of Molecular Biology and Biotechnology (I.M.B.B.) in the Foundation of Research and Technology Hellas (F.O.R.T.H). Since 2019, the lab is also part of the Biology Department, University of Crete to study the Microbiology & Host – Microbe Interactions and teach the Microbiology class in the undergraduate curriculum.
Our lab welcomes highly motivated individuals who wish to address important biological questions, relevant to the lab’s fields in a friendly and international environment.
If you are interested in joining us as a PostDoc, MSc/PhD student or Research Assistant, please send an email to: p.sarris[at]imbb.forth.gr to further discuss projects and funding opportunities. Moreover if you wish to get in touch with us for potential co-operations or new project proposals, you are strongly encouraged to do so!
Location
Lab E202, Department of Biology, University of Crete
Voutes University Campus, GR-70013,P.O.Box 2208, Heraklion, Crete, Greece
Tel: +302810394356
Teaching
Microbiology
The microbiology class is taught in the 3rd semester of the undergraduate studies in Biology, UoC. It contains lectures on the chemical and structural basis of microorganisms, including macromolecules, cell membranes, walls, and movement mechanisms. It dives into molecular biology principles, such as genetic information flow, gene regulation, and microbial energetics, including metabolism and redox processes. The course also explores genetic engineering, human-microbe interactions, microbial toxins, immunology, epidemiology, virology, and mycology, providing a comprehensive understanding of microbial biology and biotechnology applications.
See more →
MSc Studies
- Molecular & Applied Plant Biology-Green Biotechnology
- Molecular Biology – Biomedicine
Apply →
Doctoral studies
Explore many possibilities for a PhD in our lab.
Contact →
Lab rotations
About →
Lab Photos